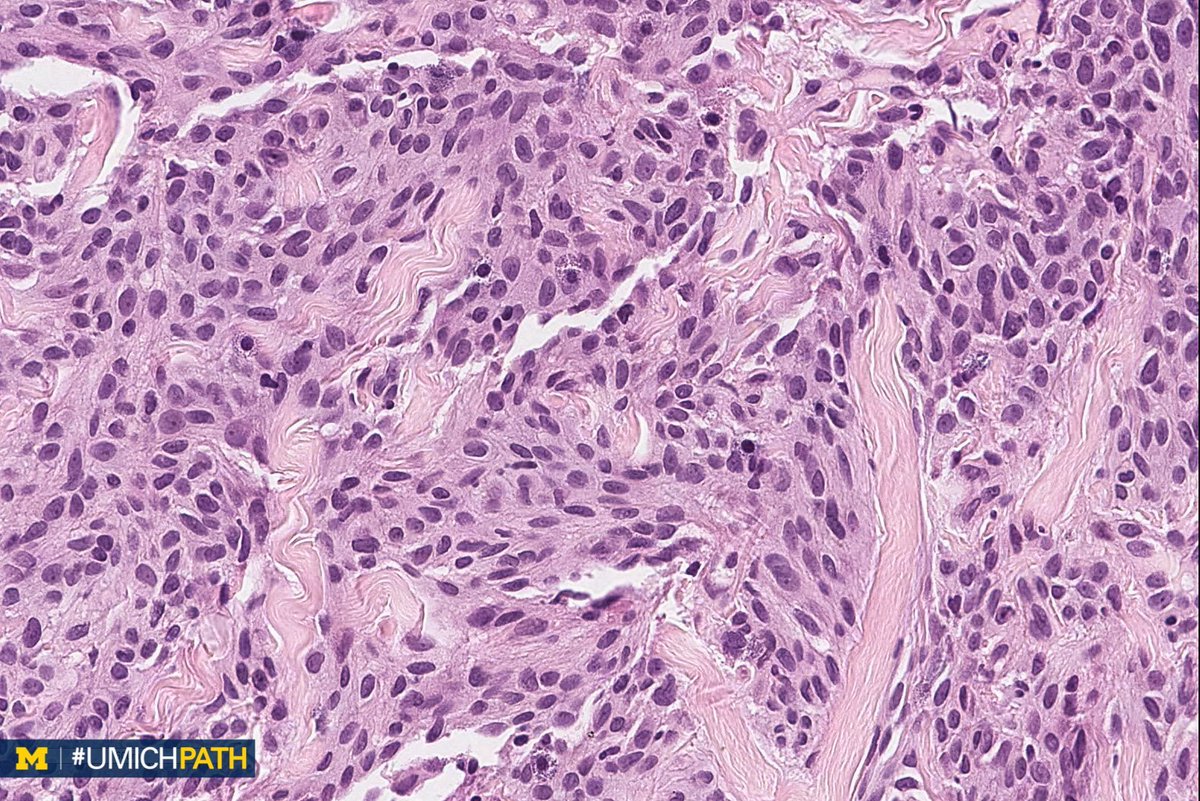
UMichPath's tweet image. 🔬#BreastPath, Day 2

➡️What’s your #DailyDx of this breast core biopsy?

➡️What stain is typically positive, and what recurrent genetic alteration is associated?

➡️We’ll tweet the answers, some quick facts, and the next case tomorrow! #UMichPath

#dailydx search results
It's a pleasure sir! The #DailyDx is a legacy that is encouraging all active students of pathology worldwide.
🔬#BreastPath, Day 4 ➡️What’s your #DailyDx of this breast lumpectomy? ➡️What ER/PR/HER2 staining pattern do you expect? E-cadherin? ➡️We’ll tweet the answers, some quick facts, and the next case tomorrow! #UMichPath



It's been a pleasure! You have enriched my training with your #DailyDx teachings!
A: (Müllerian) adenosarcoma. Malignant stroma w/ associated benign epithelium (endometrioid or metaplastic); has “Phyllodes-like” architecture w/ stromal condensation. Can be low grade or have sarcomatous overgrowth (>25%) w/ high grade or heterologous sarcoma. #GYNPath #DailyDx



🔬#BreastPath, Day 2 ➡️What’s your #DailyDx of this breast core biopsy? ➡️What stain is typically positive, and what recurrent genetic alteration is associated? ➡️We’ll tweet the answers, some quick facts, and the next case tomorrow! #UMichPath



We're sharing 2 cases today since we missed #GYNPath Day 5 last week. What’s your #DailyDx of this uterine mass? We’ll tweet the answer and some quick facts tomorrow! #UMichPath




#DailyDx is amazing!!! Kudos @UMichPath @codyscarter @Melonfeast
At #USCAP2018 and interested in pathology on social media? Connect with #UMichPath fellows Dr. Cody Carter (@codyscarter) and Dr. Ellen East (@Melonfeast), the pathologists behind our #DailyDx Twitter series!
A: Lung Adenocarcinoma (in situ): Images showing emphysematous, lepidic growth pattern w/ increased presence of macrophages in the alveolar spaces, and a close-up of lepidic growing tumor cells around a blood vessel. @LungAssociation @UMRogelCancer #PulmonaryPath #DailyDX
@Melonfeast and @codyscarter really put a ton of effort into #DailyDx. Well deserved break!!
Theme this week: Breast pathology What’s your #DailyDx of this breast biopsy? What stain would you order to confirm? We’ll tweet the answer, some quick facts, and the next case tomorrow! #UmichPath #BreastPath



Can you diagnose today's patient? Play at: electiv.app/dailydx #USMLE #DailyDx #PLAB
electiv.app
DailyDx — Can You Diagnose Today's Patient?
A daily clinical vignette challenge. Read the clues, make your diagnosis.
🔬#BreastPath, Day 5 ➡️What’s your #DailyDx of this nipple biopsy? ➡️What pattern of CK5/6, ER would you expect? ➡️We’ll tweet the answers, some quick facts, and the next case this weekend! #UMichPath



🔬#GYNPath, Day 4. ➡️What’s your #DailyDx of this uterine mass? ➡️What immunohistochemical stain would you order? ➡️We’ll tweet the answer, some quick facts, and the next case tomorrow! #UMichPath



I miss the @UMichPath #DailyDx 😞 It was quite challenging and at the same time highly motivational. It became my daily source of learning new entities. At a time I think I developed a bond with #UMich 😁🙈(like I was a trainee there😂).
A: Lipoleiomyoma. A variant of uterine leiomyomata. Gross: Well circumscribed mass with alternating yellow and white areas. Histo: Variable admixture of bland smooth muscle cells and adipocytes. Very rarely can have glandular elements (adenolipoleiomyoma). #GYNPath #DailyDx

Want to know the answer to this #DailyDx case? Check out the thread below! 👇
What’s your #DailyDx of this pelvic peritoneum biopsy, post radical cystectomy? What immunoprofile and histologic characteristics would you expect? We will tweet the answers and some quick facts later this week! #UmichPath | @MiPathKunju




Can you diagnose today's patient? Play at: electiv.app/dailydx #USMLE #DailyDx #PLAB
electiv.app
DailyDx — Can You Diagnose Today's Patient?
A daily clinical vignette challenge. Read the clues, make your diagnosis.
Can you diagnose today's patient? Play at: electiv.app/dailydx #USMLE #DailyDx #PLAB
electiv.app
DailyDx — Can You Diagnose Today's Patient?
A daily clinical vignette challenge. Read the clues, make your diagnosis.
The month of October has been very good to me as far as DX. I have acquired over a dozen new countries so far. I would like to thank dailydx on twitter/x for posting new dxpeditions that I would have never known of. #dailydx
E51D is On the Air! More radios come on ~ 0200z. This is the Logo for the RIB and nature of the Remote Operation. A FB team of ops together again for another DXpedition. #hamradio is fun again. CU in the piles. #dxworld #dailydx

4750 kHz Bangladesh Betar good signal this evening. #DailyDX youtube.com/watch?v=kFRTz5…
youtube.com
YouTube
4750 kHz Bangladesh Betar good signal
W3UR - Bernie of the #DailyDX will be the keynote speaker at the #W8DXCC convention on August 28th. See swodxa.org/w8dxcc for details.

W3UR - Bernie of the #DailyDX will be the keynote speaker at the #W8DXCC convention on August 28th. He will be giving an update on the Top 10 most Wanted! See swodxa.org/w8dxcc for details.

W3UR - Bernie of the #DailyDX will be the keynote speaker at the #W8DXCC convention on August 28th. See swodxa.org/w8dxcc for details.

I miss the @UMichPath #DailyDx 😞 It was quite challenging and at the same time highly motivational. It became my daily source of learning new entities. At a time I think I developed a bond with #UMich 😁🙈(like I was a trainee there😂).
I learnt more from #DailyDx than from my real life cases! I wish it will make a come back someday.
@oluwato44343314 Here is another institution that shared a great deal educational materials on #PathTwitter through their #DailyDx and #COTW series. You should try them out too☺️ #PathMatch21 @codyscarter
Want to know the answer to this #DailyDx case? Check out the thread below! 👇
What’s your #DailyDx of this pelvic peritoneum biopsy, post radical cystectomy? What immunoprofile and histologic characteristics would you expect? We will tweet the answers and some quick facts later this week! #UmichPath | @MiPathKunju




Ready for the answers to this #DailyDx case? Here we go! What you are seeing is a Plasmacytoid Urothelial Carcinoma. #UmichPath | @MiPathKunju
What’s your #DailyDx of this pelvic peritoneum biopsy, post radical cystectomy? What immunoprofile and histologic characteristics would you expect? We will tweet the answers and some quick facts later this week! #UmichPath | @MiPathKunju




A: Lung Adenocarcinoma (in situ): Images showing emphysematous, lepidic growth pattern w/ increased presence of macrophages in the alveolar spaces, and a close-up of lepidic growing tumor cells around a blood vessel. @LungAssociation @UMRogelCancer #PulmonaryPath #DailyDX
🔬#PulmonaryPath: What's Your #DailyDX? ➡️ The most frequent type of lung cancer, about 50%. ➡️ Also most prevalent in cancer types: prostate, pancreatic, esophageal, and colorectal. ➡️We’ll tweet the answers, some quick facts, and the next case tomorrow! #UMichPath



#DailyDx Team meets @SUNYUpstatePath! Great to meet you Michael! Good luck with everything. @bluehatcomics85 #ascp2018 #mottirl

Happy #InternationalPathologyDay! Thanks to all members of the LAB TEAM for helping patients receive the best diagnoses. (& for making the lab such an awesome place to work!) Also, big thanks to everyone that helped me get to 1000 followers & for following #DailyDx! 👏🏻 🙏🏻 👏🏻 🙏🏻

E51D is On the Air! More radios come on ~ 0200z. This is the Logo for the RIB and nature of the Remote Operation. A FB team of ops together again for another DXpedition. #hamradio is fun again. CU in the piles. #dxworld #dailydx

I like the #DailyDx series from @UMichPath so much. The cases are great and very educational. But there is always somebody who already answered the questions that I know. Oh, life is so competitive...
Spitting image right? 😆 My first foray into #pixelart. If you liked #DailyDx, please consider following my new project @8bitPathology! (and keep following @UmichPath, they are fantastic!) #8bitPath #8bitPathology #ASCP40UnderForty


New #DailyDx. 40yo woman with an ovaric mass (18 cm). Very impressive case...what’s your #diagnosis ? #gynpath #Gynecology #GIPAth #pathology #diagnosticar




We're sharing 2 cases today since we missed #GYNPath Day 5 last week. What’s your #DailyDx of this uterine mass? We’ll tweet the answer and some quick facts tomorrow! #UMichPath




🔬#BreastPath, Day 4 ➡️What’s your #DailyDx of this breast lumpectomy? ➡️What ER/PR/HER2 staining pattern do you expect? E-cadherin? ➡️We’ll tweet the answers, some quick facts, and the next case tomorrow! #UMichPath



🔬#PulmonaryPath: What's Your #DailyDX? ➡️ The most frequent type of lung cancer, about 50%. ➡️ Also most prevalent in cancer types: prostate, pancreatic, esophageal, and colorectal. ➡️We’ll tweet the answers, some quick facts, and the next case tomorrow! #UMichPath



A: (Müllerian) adenosarcoma. Malignant stroma w/ associated benign epithelium (endometrioid or metaplastic); has “Phyllodes-like” architecture w/ stromal condensation. Can be low grade or have sarcomatous overgrowth (>25%) w/ high grade or heterologous sarcoma. #GYNPath #DailyDx



🔬#BreastPath, Day 5 ➡️What’s your #DailyDx of this nipple biopsy? ➡️What pattern of CK5/6, ER would you expect? ➡️We’ll tweet the answers, some quick facts, and the next case this weekend! #UMichPath



A: Uterine tumors resembling ovarian sex cord tumors (UTROSCT). A rare mesenchymal tumor with epithelial-like cells resembling ovarian sex cord tumors. IHC: Sex cord markers are specific, but not always positive. CD10 frequently positive. #GYNPath #DailyDx (H/T @Eggmcmullen)

Theme this week: Breast pathology What’s your #DailyDx of this breast biopsy? What stain would you order to confirm? We’ll tweet the answer, some quick facts, and the next case tomorrow! #UmichPath #BreastPath



🔬#GYNPath, Day 2 ➡️What’s your #DailyDx of this uterine mass? ➡️We’ll tweet the answer, some quick facts, and the next case tomorrow! #UMichPath



🔬#BreastPath, Day 2 ➡️What’s your #DailyDx of this breast core biopsy? ➡️What stain is typically positive, and what recurrent genetic alteration is associated? ➡️We’ll tweet the answers, some quick facts, and the next case tomorrow! #UMichPath

🔬#GYNPath, Day 4. ➡️What’s your #DailyDx of this uterine mass? ➡️What immunohistochemical stain would you order? ➡️We’ll tweet the answer, some quick facts, and the next case tomorrow! #UMichPath



A: Lipoleiomyoma. A variant of uterine leiomyomata. Gross: Well circumscribed mass with alternating yellow and white areas. Histo: Variable admixture of bland smooth muscle cells and adipocytes. Very rarely can have glandular elements (adenolipoleiomyoma). #GYNPath #DailyDx

A: PEComa. A rare tumor with perivascular epithelioid cell differentiation. Aggressive behavior predicted by size >5 cm, infiltrative growth, hypercellularity, mits (>1/50 HPF), high-grade nuclei, and necrosis. IHC: Positive for sm. muscle & melanocytic markers. #GYNPath #DailyDx

🔬 Oral #Pathology, Day 5 ➡️ What’s your #DailyDx of this tongue lesion? ➡️ We’ll tweet the answer and some quick facts tomorrow! #UMichPath #ENTPath




Something went wrong.
Something went wrong.
United States Trends
- 1. Good Thursday N/A
- 2. Kawhi N/A
- 3. Happy Friday Eve N/A
- 4. Clippers N/A
- 5. Steph N/A
- 6. Al Horford N/A
- 7. Earn Now N/A
- 8. SimpleChain Testnet N/A
- 9. Warriors N/A
- 10. Darby N/A
- 11. Haachama N/A
- 12. Catholic Charities N/A
- 13. Ty Lue N/A
- 14. Allocation N/A
- 15. #DubNation N/A
- 16. #TomodachiLife N/A
- 17. The New One N/A
- 18. Munoz N/A
- 19. Spaceballs N/A
- 20. #AEWDynamite N/A




















